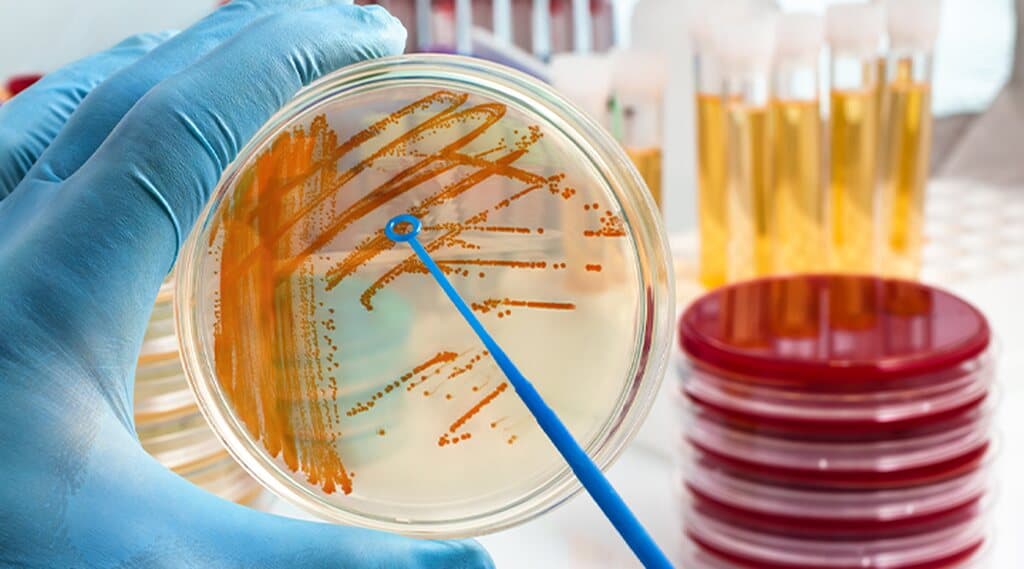
Bakteriuria

Mocz – najważniejsze parametry. Co warto wiedzieć?
Mocz jest płynem powstającym w procesie filtrowania (oczyszczania) krwi przez nerki. W skomplikowanym procesie filtracji, substancje nadal potrzebne w funkcjonowaniu organizmu (np. białka, glukoza) są odzyskiwane i powracają do krwioobiegu. Wszystkie niepotrzebne, wręcz toksyczne produkty przemiany materii zachodzącej w organizmie (np. mocznik) trafiają do moczu, który wydalany jest w ilości ok. 1,5 litra na dobę. Co powinno znajdować się w moczu, a co świadczy o procesie chorobowym?

Etapy powstawania moczu
Filtracja, czyli wieloetapowy proces powstawania moczu odbywa się w wyspecjalizowanych strukturach, określanych mianem nefronów. Nefron to podstawowa jednostka budująca nerkę, w skład której wchodzi kłębuszek oraz cewki nerkowe. W pierwszym etapie filtrowania krwi przez kłębuszki nerkowe powstaje tzw. mocz pierwotny. Poza toksycznymi produktami przemiany materii zawiera on sole mineralne, aminokwasy, witaminy i wodę, czyli produkty, które ponownie mogą być wykorzystane przez organizm.
Drugi etap filtracji zachodzi w cewkach nerkowych i polega na odzyskiwaniu życiowo ważnych substancji z moczu pierwotnego w tzw. procesie wchłaniania zwrotnego. Po zakończeniu tego procesu powstaje końcowy, zagęszczony produkt filtracji tzw. mocz ostateczny.
Kolor moczu – dlaczego mocz jest żółty?
Mocz powinien mieć zabarwienie słomkowe lub jaskrawo żółte. Za żółtawy kolor moczu odpowiada bilirubina, czyli produkt powstający w wyniku przemian hemoglobiny – białka zawartego w krwinkach czerwonych. Ciemniejsze – bursztynowe lub ciemnożółte zabarwienie moczu jest przesłanką świadczącą o zbyt małej ilości spożywanych płynów. Może być także spowodowane zwiększonym wydalaniem bilirubiny do moczu, co jest konsekwencją chorób wątroby lub nasilonego procesu niszczenia krwinek czerwonych tzw. hemolizy.
Inna niż żółta barwa moczu może być wynikiem obecności w moczu krwinek czerwonych (krwiomocz – czerwony), zjedzenia buraków (czerwony) lub szpinaku (zielony), czy też spożywania leków (furazydyna – pomarańczowy).
Ciężar właściwy moczu
Ciężar właściwy moczu to nic innego jak masa jednego mililitra moczu. Prawidłowy ciężar właściwy moczu powinien mieścić się w przedziale od 1,020 do 1,035 g/ml i zależy przede wszystkim od stopnia zagęszczenia moczu i ilości spożywanych płynów (np. po 8h bez płynów powinien przekraczać >1,020 g/ml).
Obniżony ciężar właściwy może świadczyć zarówno o dużej ilości spożywanych płynów, jak również być wynikiem choroby nerek, np. jej przewlekłej niewydolności i utraty zdolności do zagęszczania moczu. Wartości >1,035 g/ml mogą wynikać z obecności w moczu substancji, które nie powinny się w nim znajdować np. glukozy lub białka.
Ph moczu
Mocz zdrowego człowieka powinien mieć odczyn lekko kwaśny (6 – 6,5). Kwaśne pH moczu to jedna z fizjologicznych barier układu moczowego, zapobiegająca w naturalny sposób przyleganiu bakterii do nabłonka układu moczowego. Zasadowe pH moczu często jest wynikiem stosowania diety wegetariańskiej, może także świadczyć o bakteryjnym zakażeniu układu moczowego.
Zapach moczu
Mocz zdrowego człowieka ma charakterystyczny, lekko kwaśny zapach. Zmiana zapachu jest objawem niepokojącym, który może świadczyć o toczącym się w organizmie procesie chorobowym. U osób z niekontrolowaną cukrzycą, obecność glukozy w moczu oraz ciał ketonowych może nadawać mu owocową lub acetonową woń.
Zapach amoniaku może świadczyć o bakteryjnym zakażeniu układu moczowego. „Mysi” zapach moczu u noworodka jest objawem choroby genetycznej, czyli fenyloketonurii. Zapach moczu może zmieniać się pod wpływem diety (czosnek, szparagi, chrzan) oraz stosowanej farmakoterapii.
Badanie moczu
Wymienione cechy fizyczne i parametry moczu, oceniane są w tzw. badaniu ogólnym moczu. Jest to badanie, które ze względu na ogromną diagnostyczną wartość wyników jest jedną z najczęściej zlecanych i wykonywanych analiz laboratoryjnych. Jest również badaniem przesiewowym, pozwalającym na wykrycie patologii układu moczowego jeszcze w okresie bezobjawowym. Wykonuje się go głównie w laboratoriach medycznych w pracowni analitycznej, ale także na Oddziałach Intensywnej Opieki Medycznej.
Po odpowiednim poinstruowaniu, badanie ogólne moczu po części może zostać wykonane samodzielnie w domu pacjenta. Poranną próbkę moczu do analizy ogólnej pozyskuje się głównie w trakcie mikcji oraz zabiegów: cewnikowania lub przez nakłucie nadłonowe. Początkowa analiza odbywa się przy użyciu wieloparametrowych testów paskowych, wykrywających związki chemiczne i składniki moczu, czyli albuminę, azotyny, glukozę, bilirubinę, ciała ketonowe, ciężar właściwy, pH, urobilinogen, kwas askorbinowy, ale także erytrocyty i leukocyty.
Reakcja chemiczna odczynników umieszczonych na pasku testowym ze związkami zawartymi w moczu, prowadzi do zmiany zabarwienia pola testowego. Wyniki otrzymuje się przez odczytanie za pośrednictwem analizatora lub wzroku, zmiany zabarwienia pól reakcyjnych. Drugi etap badania polega na mikroskopowej ocenie osadu moczu, który uzyskuje się po odwirowaniu próbki w wystandaryzowanych warunkach.
Na tym etapie badania zlicza się w określonej ilości pól widzenia elementy morfotyczne osadu (krwinki białe, czerwone, komórki nabłonkowe, wałeczki, pasma śluzu, bakterie, kryształy). Mikroskopowe badanie osadu pozwala ustalić pochodzenie erytrocytów i komórek nabłonkowych, oraz przed wykonaniem badania mikrobiologicznego bliżej określić przyczynę infekcji (bakterie, grzyby, pierwotniaki).